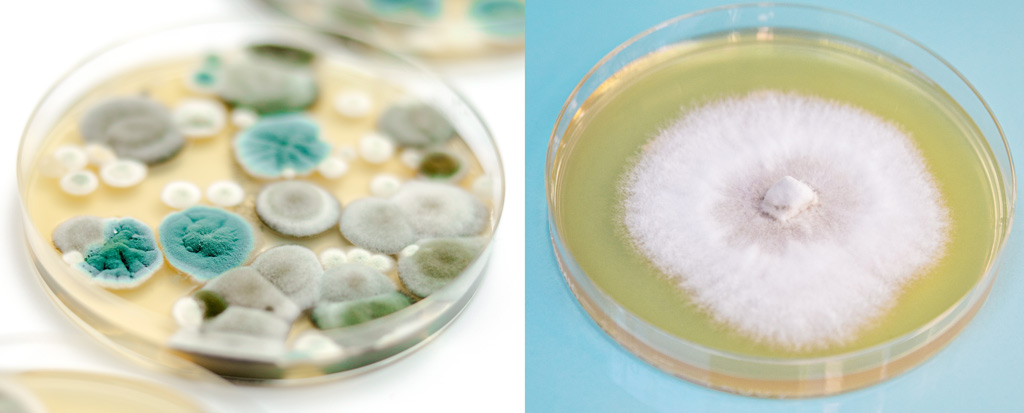
Vergelijk 2 petrischaaltjes. Links een besmet petrischaaltje met verschillende kleuren schimmel. Rechts een petrischaaltje met een succesvolle schimmelkweek.

- Beginners, gevorderden… Paddo’s kweken kan iedereen!
- Het lab in: paddo’s kweken als een pro
- Handleiding paddo’s kweken uit een sporenprint of sporenspuit
- Boodschappenlijstje
- Liquid culture maken
- Boodschappenlijstje
- Deksel bewerken voor liquid culture en substraat
- Zelf substraat maken:
- Paddo’s kweken met liquid culture: inoculeren en incuberen
- Dit zijn de stappen voor onze growkit met steriel substraat:
- Paddo’s kweken
- Uitdagende paddo growkits
- Cubensis
- Panaeolus cyanescens (Copelandia / Hawaii)
- Psilocybe azurescens en Psilocybe cyanescens
Beginners, gevorderden… Paddo’s kweken kan iedereen!
Klopt! Paddo’s kweken is niet moeilijk. Toch is er een groeiend aantal enthousiaste kwekers die niet zoveel voelen bij makkelijke growkits. Maar zelfs als je kiest voor de meer unieke growkits sta je nog best voor een uitdaging. In dit artikel vertellen we over de meer geavanceerde kweekmethodes zoals PF-Tek en andere methodes waarbij je vanuit sporen of liquid culture werkt, en later introduceren we een aantal soorten paddo’s die next level genoeg kunnen zijn.
Het lab in: paddo’s kweken als een pro
Handleiding paddo’s kweken uit een sporenprint of sporenspuit*
*Niet te verwarren met een spuit liquid culture. Die beschrijving staat verderop.
Paddo’s hebben verschillende stadia in hun leven. Volwassen paddenstoelen klappen langzaam open en laten sporen vallen die zo licht zijn dat ze met een zuchtje wind en op de rug van insecten worden meegenomen. Die sporen zijn te vergelijken met zaadjes bij planten. Wanneer sporen ontkiemen, groeit daaruit het mycelium: een netwerk van schimmeldraden dat door het substraat heen zoekt naar voeding en een geschikte leefomgeving. Pas wanneer dat mycelium groot en dicht genoeg is, schakelt het over op de volgende fase: het vormen van paddenstoelen. Wat je hier wilt leren is hoe je dat mycelium laat ontkiemen en uitbreiden met zo min mogelijk kans op besmetting of, met een deftig woord: contaminatie.
Dit wil je weten. Zo ontkiem je paddo-sporen en maak je een zuivere startcultuur.
Boodschappenlijstje
- Agar-agar (voedingsmedium voor op petrischaaltjes)
- Steriele petrischaaltjes
- Steriel mes of scalpeltje
- Parafilm of PVC-tape
- Desinfecterende alcohol (70% of hoger)
- Handschoenen en eventueel een mondmasker
- Steriele werkplek
- Was je handen goed en maak je werkplek schoon met alcohol. Bereid je agar-agar medium volgens recept voor, giet het in petrischaaltjes en steriliseer dit geheel met een snelkookpan/drukpan totdat het medium helder gestold is.
- Voer de volgende stappen uit in een zo steriel mogelijke omgeving. In laboratoria gebruikt men een flow kap of een still air box om luchtcontaminatie te verminderen.
- Verhit je mes in een vlam om het te steriliseren, laat het mes volledig afkoelen voordat je het sporenmateriaal aanraakt.
- Open de sporenprint, neem een zeer kleine hoeveelheid sporen met het steriele mes en leg deze midden op het agaroppervlak in het petrischaaltje.
- Sluit het petrischaaltje af met parafilm of tape zodat er geen lucht of stof kan binnendringen. Zet het petrischaaltje weg op een stabiele temperatuur (bij voorkeur rond 20-25 °C) op een donkere plek.
- Na enkele dagen tot een week begint het mycelium in spierwit netwerkvorm te groeien over het agaroppervlak. Dit moet geheel wit blijven; andere kleuren duiden op contaminatie*.
Links: jammer! Deze is besmet. Rechts: gefeliciteerd, je kunt verder naar de volgende stap.
*Zelfs meesterkwekers hebben niet altijd geluk. Als het een andere kleur wordt dan wit, heb je een besmetting te pakken. Gooi die inhoud dan weg en kies een beter schaaltje of begin opnieuw met de stappen hierboven. Daarom is het raadzaam om meerdere petrischaaltjes voor te bereiden. Dan heb je meer kans op succes.
Liquid culture maken
Liquid culture is een vloeibaar voedingsmedium waarin mycelium actief kan groeien. Het voordeel van liquid culture is dat je het makkelijk kunt toevoegen aan een voedingsbodem. Dat noemen we inoculeren. Liquid culture groeit sneller en geeft betrouwbaardere resultaten dan direct sporen toevoegen omdat er al mycelium aanwezig is. Het maken van een goede liquid culture hangt volledig af van steriel werken en de juiste voedingsoplossing.
Boodschappenlijstje
- 2 Glazen potten met metalen draaideksels
- Een hersluitbare rubberen injectiepoort
- Een filtersticker met een maaswijdte van maximaal 0,4 micron
- Steriel mes of scalpel
- Alcohol en gedesinfecteerde handschoenen
- Recept voor liquid culture medium (bijvoorbeeld water plus light malt extract of andere suikers)
- Druksterilisator of snelkookpan
Voor liquid culture en later substraat moet het deksel van je pot twee doorgangen hebben: een voor verse lucht via een filter en een voor de spuitnaald. Als je ook je paddenstoelen uit een pot wilt laten groeien, heb je in ieder geval 2 potten nodig waarbij je dezelfde voorbereiding doet. Belangrijk is dat je in ieder geval 1 deksel heel houdt.
Deksel bewerken voor liquid culture en substraat
Snijd een gat in het deksel net kleiner dan de filtersticker zodat de sticker strak past. Snijd vervolgens een gat voor de injectiepoort en plaats deze stevig. Gebruik voor elke pot een nieuw filter en injectiepoort om besmetting te voorkomen.

Een deksel met een filtersticker en een rubberen injectiepoort die zichzelf opnieuw afsluit als je de naald eruit haalt.
Doe agar-agar in een pot en leng aan met gekookt en afgekoeld water. De verhouding is idealiter 4% agar-agar op 96% water; iets minder sterk dan 1 op 20 dus. Schroef een heel deksel (zonder gaten) goed op de pot.
Zet de gesloten pot met voeding en het bewerkte deksel met gaten (maar zonder filter en injectiepoort) in de snelkookpan en steriliseer dit 15-20 minuten bij een druk van 15 psi of 1035 millibar. Laat daarna het deksel met de gaten drogen op een schoon oppervlak (niet drogen met een doek) en plaats dan de nieuwe steriele filtersticker en injectiepoort. Laat de pot volledig afkoelen tot kamertemperatuur zonder de pot te openen.
Open vervolgens in een steriele omgeving een volledig wit gekoloniseerde agarplaat en snijd met een steriel mesje een stukje agar met zuiver mycelium eruit. Plaats dit stukje in de pot met het vloeibare medium. Verwissel het deksel voor het deksel met filter en injectiepoort. Sluit en verzegel de pot met parafilm of tape en bewaar deze op kamertemperatuur. Schud de pot dagelijks zachtjes zodat het mycelium door het medium verdeeld wordt. Pas met schudden wel op dat het niet tegen het filter aan klotst! Binnen dagen tot weken groeit het mycelium uit tot een troebele cultuur met witte vlokken. Wanneer dit is bereikt is de liquid culture klaar voor gebruik.
Zelf substraat maken:
Als je zelf substraat (voedingsbodem) maakt en wilt kweken in een glazen pot, moet je ook een deksel voorbereiden zoals eerder beschreven. Vul een glazen pot met:
- Perliet: ongeveer 1 deel, voor vochtbehoud en luchtigheid.
- Vermiculiet: ongeveer 2 delen, voor luchtigheid en vochtbehoud.
- Voeding (bijvoorbeeld gewelde zilvervliesrijst of roggemeel)*: ongeveer 1 deel, als voedselbron voor mycelium.
- Water: voeg water toe totdat het mengsel vochtig is maar niet drijfnat.
*Er zijn vele opties voor een voedingsbodem. Eigenlijk wordt er altijd een vorm van graan gebruikt. Sorghum, tarwe, gerst, roggemeel, zilvervliesrijst en zelfs vogelzaad werken. Maar je moet het wel vochtig maken. Hele granen moet je ook wellen; weken in warm water. We hebben weleens een klant aan de lijn gehad die een spuit liquid culture rechtstreeks in een zak zilvervliesrijst had gezet: dat werkt niet om 2 redenen: je kunt alleen steriele voedingsbodem gebruiken en de granen moeten geweld zijn. Verder kun je het beste perliet en vermiculiet toevoegen om de eigenschappen van de bodem te verbeteren. Al deze moeite doe je namelijk niet voor 1 paddenstoel, maar een grote opbrengst. Volg daarom de stappen zoals we die beschrijven en probeer geen bochten af te snijden.
Zet de gesloten pot met voeding en het bewerkte deksel met gaten (maar zonder filter en injectiepoort) in de snelkookpan en steriliseer dit 15-20 minuten bij een druk van 15 psi of 1035 millibar. Laat daarna het deksel met de gaten drogen op een schoon oppervlak (niet drogen met een doek) en plaats dan de nieuwe steriele filtersticker en injectiepoort. Laat de pot volledig afkoelen tot kamertemperatuur zonder de pot te openen.
Paddo’s kweken met liquid culture: inoculeren en incuberen
Als je een kant-en-klare spuit liquid culture koopt: Naalden in een liquid culture setje worden steriel verpakt. Open deze pas als je helemaal klaar bent voor het inspuiten.
- Als je verder gaat vanaf het vorige stukje: vervang in een steriele omgeving in een vloeiende beweging het dichte deksel voor het deksel dat je hebt voorzien van een nieuw filter en injectiepoort.
- Je kunt ook een growkit kopen met alleen steriel substraat. Die heeft al een injectiepoort en filter in het deksel. Na het inoculeren kun je die terug in de doos doen en op een donker plekje bewaren.
Nu spuit je met een steriele spuit met liquid culture door de injectiepoort van de pot of de bak met steriel substraat.
Dit zijn de stappen voor onze growkit met steriel substraat:
- Ontsmet het witte rondje op het deksel van de steriele growkit met een alcoholdoekje.
- Zet de naald op je spuit liquid culture.
- Steek de naald schuin door het witte rondje en spuit de cultuur volledig in de growkit.
Tip: De schimmel groeit het snelst door aan verschillende kanten te spuiten. Maar haal de naald er niet tussentijds uit. Draai de naald verschillende richtingen op terwijl hij er nog in zit en spuit de liquid culture helemaal leeg.
Laat het deksel gesloten tot en met het moment dat de hele pot of de hele bak met substraat wit is van de alsmaar groeiende schimmel. Paddo’s zullen niet groeien als de bak niet helemaal wit is. Hoe lang het duurt voordat de schimmel is volgroeid is sterk afhankelijk van de ondergrond (substraat) en de temperatuur. Hoe warmer, hoe sneller. Maar er zit beslist een maximum aan. En omdat schimmel een beetje warmer wordt als het groeit, raden we je niet aan om tijdens deze stap verwarming te gebruiken zoals een warmtemat. Kamertemperatuur (19-21 graden Celsius) moet voldoende zijn. In de meeste gevallen duurt het 4 tot 6 weken voordat de bak compleet is gekoloniseerd, maar nogmaals: het is afhankelijk van de omstandigheden.

Paddo’s kweken
Als je eenmaal een pot of bak met substraat hebt die volledig wit is gekoloniseerd, sta je in het geval van je potje voor een interessante keuze. Hoe ga je er paddo’s uit laten groeien? Een methode is de pot in een hersluitbare plastic zak of kunststof doos te plaatsen en alleen het deksel te openen zodat de paddo’s eruit groeien. Een andere methode is de monotub techniek: je schudt de cake voorzichtig uit de pot op aluminiumfolie en zet er een grote plastic bak overheen. Voor verse lucht maak je enkele gaten in de bak en bedek je ze met filterstickers. Het eerste stadium van de vorming van paddo’s heeft genoeg vocht nodig, wat je kan geven door meerdere keren per dag te sprayen met een plantenspuit op nevelstand.

Voor een bak met steriel substraat die na enkele weken volledig wit is geworden, hoef je eigenlijk alleen de instructies te volgen van de beginnershandleiding; Je weekt de kit 8 uur in water, haalt het deksel van de bak en plaatst deze in de meegeleverde zak, waar je een laagje water in doet voor de luchtvochtigheid.
Tip: Coldshock
Onze growkits waarin al mycelium gegroeid is, bewaren we bij 4 graden Celcius. Om jouw kersverse pot of bak met je huisgekweekte mycelium de beste start te geven, kun je de herfst simuleren door de pot of bak vlak voor de start van deze stap 24 uur in de koelkast te zetten. Doe het 8 uur weken nadat de kit uit de koelkast komt.
Of je nu een bak of zak kiest: zorg dat er voldoende vocht aanwezig is door de eerste dag met een plantenspuit op de nevelstand 2 of 3 keer te sprayen.
Ga nu verder met de laatste stappen uit de handleiding voor beginners. Met een beetje geduld en wat aandacht heb je binnen 2 tot 3 weken prachtige zelfgekweekte paddo’s.

Weten hoe sterk je paddo’s zijn? Test ze thuis met de makkelijke PsiloQ test. Daarmee krijg je een goede indicatie van de concentratie psilocybine in je zelfgekweekte paddo’s.
Uitdagende paddo growkits
In onze blog paddo’s kweken voor beginners, las je dat Psilocybe cubensis de soort paddo’s is waar je de meeste keuze hebt van growkits. Dat is niet zomaar, want deze soort paddenstoelen is bijzonder goed te kweken in een bak met een steriele ondergrond. Die methode is zo makkelijk dat veel hobbyisten over de hele wereld al kweeksets met elkaar hebben gekruist om zo nieuwe variëteiten op de markt te brengen. Toch zijn variëteiten van cubensis nog steeds van dezelfde soort.
Cubensis
Binnen de cubensis paddo growkits zijn er een paar variëteiten die eruit springen.
B+ staat erom bekend makkelijk te kweken te zijn. Met “makkelijk” wordt bedoelt dat de paddo’s vrij resistent tegen besmettingen zijn, toe kunnen met minder dan ideale omstandigheden en een kortere tijd hebben tot de oogst. Dat laatste maakt de kans op besmettingen ook kleiner. Want hoe korter de blootstelling aan de omgeving, hoe groter de kans op succes.
Penis Envy staat erom bekend moeilijk te kweken te zijn als je alleen kijkt naar de cubensis soort. Vandaar dat het zo lang heeft geduurd (tientallen jaren!) voordat er growkits met Penis Envy genetica op de markt kwamen. Wij waren dan ook blij verrast dat het is gelukt en trots dat we ze nu aan je kunnen verkopen. Wat Penis Envy volgens ons “moeilijk” maakt, is dat het 3-5 weken kan duren voordat je de eerste paddo’s ziet. Daarnaast kost het tijd om die dikke stammen te maken. Die zijn veel dikker dan de doorsnede andere cubensis zoals een Golden Teacherof McKennaii. De beloning zit hem in de concentratie psilocybine. Penis Envy kan aanzienlijk sterker zijn dan zijn soortgenoten, door de grotere paddenstoel die meer tijd nodig heeft om te kunnen worden geoogst. Dutch-Headshop cubensis kweeksets herken je aan een gele sticker.

Panaeolus cyanescens (Copelandia / Hawaii)
Een soort waarbij extra aandacht nodig is Panaeolus cyanescens. Een van de redenen is dat het een soort is die graag in de aarde wroet voor extra voedingsstoffen. Als de paddenstoel geen aarde heeft maar op dezelfde bodem wordt gekweekt, komen er minder of zelfs helemaal geen paddo’s boven.
Toch zijn er complete growkits van te koop waarmee je maar met 1 stapje extra werk paddo’s kunt kweken: je verspreidt de meegeleverde aarde over de voedingsbodem voordat je de kweekbak in de zak doet. Raak die aarde niet aan, maar strooi het uit over de bovenkant.
Panaeolus cyanescens is een teer, klein stoeltje. Maar uiterlijk is zeer bedrieglijk, want deze kleine jongens zijn per gram veel sterker dan een Psilocybe cubensis! De opbrengst kan minder zijn op de weegschaal, maar je haalt er vaak meer trips uit.
Momenteel hebben we (nog ) geen Dutch-Headshop Panaeolus cyanescens kweeksets. Maar zodra we die hebben, zal je deze kweekmethode herkennen aan de roze sticker.
Psilocybe azurescens en Psilocybe cyanescens
Helemaal next level zijn deze soorten. Nauw aan elkaar verwant zijn Psilocybe azurescens en Psilocybe cyanescens. Azurescens is zelfs op het moment van schrijven gekroond tot de meest sterke paddenstoel ter wereld!
Deze cyanescens moet je overigens niet verwarren met die uit het vorige kopje. Panaeolus c is op zoveel manieren zo anders dan Psilocybe c, dat de kweekmethode ook compleet verschillend is. Kijk maar naar deze foto’s van de paddenstoelen in het wild:

Van links naar rechts: Psilocybe cubensis, Psilocybe cyanescens, Psilocybe azurescens (let op het puntje) en de slanke witte Panaeolus cyanescens.
Dat de namen op elkaar lijken zegt dus niet zoveel over het uiterlijk of de kweekmethode.
Zowel Psilocybe azurescens als Psilocybe cyanescens zijn kieskeurig qua voeding. Je kweekt ze het grootste gedeelte van de tijd buiten. Ze houden, als “het wortelgestel” eenmaal volwassen genoeg is, niet van een steriele bodem. Daarnaast zijn ze, in tegenstelling tot de hierboven genoemde soorten, dol op houtsnippers. Beukenhout is als kaviaar voor ze!
Deze soorten paddo’s worden geleverd in een bakje met broed; heel ander spul dan gekoloniseerd substraat. Dat laatste is een moeilijk woord voor zeggen dat het direct klaar is voor paddo’s lanceren. Broed daarentegen is een soort starter waarmee je eerst een grotere kolonie schimmel moet maken. Dat kun je doen in een grote plastic bak die je eerst vult met vochtig beukenhout dat is gesteriliseerd. De schimmeldraden (mycelium) zijn namelijk nog niet sterk genoeg om tegen de grote boze wereld van micro-organismen op te boksen. Steriliseren van het beukenhout kun je het beste doen in een grote snelkookpan. Die heb je al voor 50 Euro online. Het hoeft geen high-end ding te zijn, maar wel groot.
Beukenhout gesteriliseerd? Giet het overtollige water af en stort de helft van de snippers in je kweekbak. Kieper de inhoud van je bakje paddenstoelen broed erin en dek af met de overgebleven houtsnippers. Zet een deksel op de bak, maar op een klein kiertje voor de verse lucht. Laat nu enkele weken tot maanden (ja, maanden) staan.
Je kunt dit proces het hele jaar starten, maar sommigen is het gelukt om in december te starten en het jaar erop in september (al) een kleine oogst te plukken. Het vereist wat geduld, maar daar staat tegenover dat na 1 oogst, ieder jaar een grote hoeveelheid loeisterke paddo’s uit eigen tuin kunt plukken. Onbespoten, vers van het land. Het enige dat je hoeft te doen is een zakje beukenhoutsnippers toe te voegen. De volgende stappen voor de kweek en tips zoals het toevoegen van graszaadjes en afdekken met aarde lees je in het uitvoerige blog over het kweken van Psilocybe azurescens, maar die is net zo goed van toepassing op Psilocybe cyanescens.
Dutch-Headshop outdoor paddo’s zoals Psilocybe azurescens en Psilocybe cyanescens herken je aan een blauwe sticker en worden geleverd in bakjes of zakjes broed.

